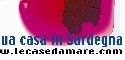
Le Case d'Amare

€ 380.000
83 m²6 locali2 bagni1° piano1
Attico in Vendita a Capo Testa con Vista Mare Mozzafiato Scopri questo ampio e luminoso attico situato a Capo Testa, un vero angolo di paradiso. Con una superficie commerciale di 83 m², questo immobile offre uno spazio generoso e confortevole, perfetto per chi cerca il massimo del relax. La bellissima vista mare è il fiore all'occhiello di questa proprietà,...